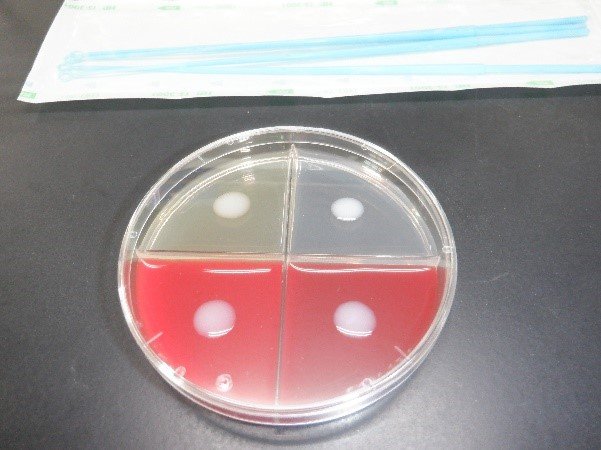
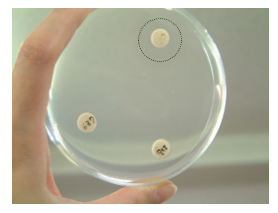

新冠牧場では乳用牛を飼養しており、日頃から牛の観察を徹底し、獣医師を中心に異常のある個体の早期発見、ワクチン接種も活用した疾病の発生予防、治療を行っています。
当場で重点的に対応している疾病は、乳房炎、蹄病です。


バルクタンク乳の定期的な検査、乳房炎原因菌やその治療に効果的な抗生物質を選択するための検査を行っています。
抗生物質を投与した場合は、抗生物質が残留していないことを確認する検査を行っています。

衛生管理区域への家畜伝染病の病原体の持ち込み・持ち出しを防ぐため、飼養衛生管理基準に基づき、畜舎周辺(衛生管理区域)への立ち入りを制限しています。当場へご来場される方は、 ご来場の皆様へ のページをご覧ください。
当場で飼養している牛群については、定期的な検査により、家畜伝染病(ヨーネ病、牛伝染性リンパ腫、サルモネラ症等)が侵入していないことを確認しています。


新冠牧場では、雌牛を飼養している第1農場で、平成28年2月5日から令和元年12月9日までに、のべ29頭のヨーネ病患畜を摘発・淘汰しました。
日高自衛防疫組合や農研機構動物衛生研究部門のご指導をいただきつつ、牛舎等の徹底した洗浄・消毒・検査、牛舎内専用の衣服や物品の整備等に取り組み、令和4年12月10日にヨーネ病非発生農場に復帰しました。
引き続き、早期の親子分離や代用初乳の給与、牛舎や作業機械の定期的な洗浄・消毒、牛群の定期的な自主検査等によりヨーネ病の清浄性維持を行うとともに、より一層の衛生管理向上の取り組みを進めていきます。


